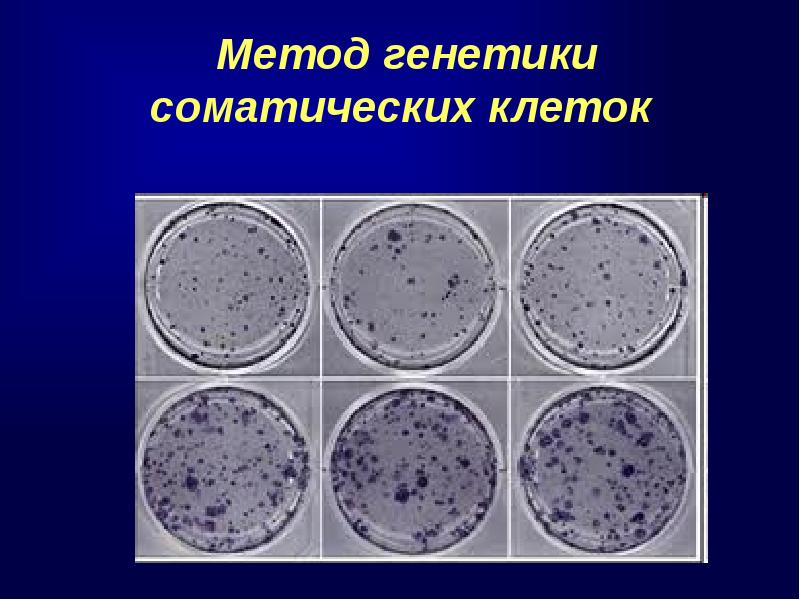

Клетка это в генетике
Шип прайм и мегатрон
Песня годзилла кто поет текст на русском
Отрицание и вердикт
Гранитная брусчатка оптом
Синее море в исполнении
Зеленые сопли температуры нет
Участок в крыму недалеко от моря
Что со слешлибом
Факты о лермонтове 4 класс короткие
Структурное звено полимера это
Пки 11 1з 1р
Коллекция geox
Буфетчица клава
Клетка это в генетике 108 фотографий